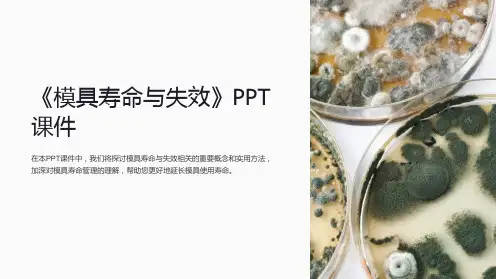

锻造模具的失效与延寿
- 格式:docx
- 大小:19.11 KB
- 文档页数:3



锻造零件失效例子
锻造零件在使用过程中可能会出现多种失效情况,以下是一些
可能的例子:
1. 疲劳失效,在零件长期受到循环载荷作用下,可能会发生疲
劳失效。
这种失效通常表现为零件出现裂纹并最终断裂。
例如,汽
车曲轴在长期高速运转下可能发生疲劳失效。
2. 变形失效,锻造零件在使用过程中可能由于受到过大的载荷
或者温度变化而发生变形失效。
例如,机械零件在受到过大载荷时
可能发生塑性变形,导致其功能失效。
3. 腐蚀失效,在恶劣的工作环境下,锻造零件可能会受到腐蚀
的影响而发生失效。
例如,金属零件在受到化学介质腐蚀时可能出
现表面损坏并最终失效。
4. 磨损失效,长期摩擦作用下,锻造零件可能会出现磨损失效。
例如,机械零件在长期高速摩擦下可能出现表面磨损,导致其使用
寿命减短。
5. 材料缺陷失效,在制造过程中,锻造零件可能由于材料内部存在缺陷而导致失效。
这种失效通常表现为零件在使用过程中突然断裂或变形。
总的来说,锻造零件失效的例子可以从疲劳、变形、腐蚀、磨损以及材料缺陷等多个方面来进行分析。
为了避免这些失效,需要在设计、制造和使用过程中加强质量控制,确保零件的可靠性和耐久性。

1.1模具的相关定义、模具寿命的基本概念模具:其是用来成型各种工业产品的一种重要工艺装备,是机械制造工业成型毛坯或零件的一种手段。
模具寿命:模具因为磨损或其他形式失效、终至不可修复而报废之前加工的产品的件数。
制件报废:模具生产出的制品出现形状、尺寸及表面质量不符合其技术要求的现象而不能使用。
模具服役:模具安装调试后,正常生产合格产品的过程。
模具损伤:模具在使用过程中,出席那尺寸变化或微裂纹、腐蚀等现象,但没有立即丧失服役能力的状态。
模具失效:模具收到损坏,不能通过修复而继续服役。
早期失效:模具未达到一定工业技术水平公认的使用寿命就不能服役时。
正常失效:模具经大量的生产使用,因缓慢塑性变形或较均匀地磨损或疲劳断裂而不能继续服役。
模具正常寿命:模具正常失效前生产出的合格产品的数目。
1.2模具失效形式基本概念模具失效:在特定负荷作用下,具有特定形状的模具材料的失效磨粒磨损:工件表面的硬突出物或外来硬质颗粒存在工件与模具接触表面之间,刮擦模具表面,引起模具表面材料脱落。
粘着磨损:工件与模具表面相对运动时,由于表面凹凸不平,某些接触点局部应力超过了材料的屈服强度发生粘合,粘合的结点发生剪切断裂而拽开,使模具表面材料转移到工件上或脱落。
疲劳磨损:两接触表面相互运动时,在循环应力的作用下,使表层金属疲劳脱落。
气蚀磨损:当模具表面与液体接触作相对运动时,接触处形成气泡,气泡破裂,产生瞬间的冲击和高温,使模具表面形成微小麻点和凹坑。
冲蚀磨损:液体和固体微小颗粒高速落下,反复冲击到模具表面,局部材料流失,在金属表面形成麻点和凹坑。
腐蚀磨损:在摩擦过程中,模具表面与周围介质发生化学或电化学反应,再加上摩擦力的机械作用,引起表层材料脱落。
断裂失效:模具在工作过程中出现较大裂纹或部分分离而丧失正常服役能力的现象。
韧性断裂:断裂前产生明显的宏观塑性变形,端口截面尺寸减少,有颈缩现象。
脆性断裂:断裂前变形量很小,没有明显的塑性变形量,端口尺寸无明显变化,不产生颈缩。

浅谈热锻模具失效的预防【摘要】本文针对锻模的几种主要失效形式,从模具材料、模具设计、模具制造和模具使用等几个方面提出了相应的预防措施,以改善模具制造质量和提高模具的使用寿命。
【关键词】模具;失效;预防措施0.引言模锻是实现模锻工艺的重要手段,在锻造生产中占有十分重要的地位。
其中模具的费用占模锻生产成本的比例达到15%~20%,因此模具的使用寿命一直受到锻造行业的高度重视。
针对模具失效报废的各种原因,提前采取相应的预防措施,可以有效的延长模具的使用寿命,从而降低生产成本,提高经济效益。
1.热锻模具失效的几种形式热锻模具的失效是指模具出现了不能通过修复手段来恢复其使用功能的损伤,也就是通常我们所说的模具损坏或报废。
锻模失效的主要形式包括:磨损、塑性变形、热疲劳裂纹、断裂。
1.1磨损磨损是模具在使用过程中,模膛表面与金属坯料接触产生相对运动,模膛表面金属逐渐被磨蚀的现象。
一般表现为刃口钝化、棱角变圆、平面下陷、表面沟痕等。
1.2塑性变形塑性变形是指模膛与金属坯料接触时,某些部位因温度急剧升高而软化或模膛本身强度不足,在较高的应力作用下模具的几何形状或尺寸发生了改变,如模膛塌陷、扩展、凸台和棱角倒塌以及凸模出现镦粗、纵向弯曲等。
1.3热疲劳裂纹热疲劳裂纹是指模膛表面在循环热应力的作用下产生循环的塑性应变,经过一定的循环次数,导致表面产生的许多细小裂纹。
1.4断裂断裂指模具受到冲击载荷时,当产生的内应力超过材料的强度极限时,从应力集中处发生开裂。
断裂一般分为脆性断裂和疲劳断裂。
2.热锻模具失效的预防措施2.1模具材料方面模具材料,是构成模具的基础,对模具的寿命有着最直接的影响。
因此,模具设计的首要任务是正确选用并合理使用模具材料,以保证模具的正常使用寿命。
模具选材一般需要满足三个条件:满足耐磨性,强韧性等工作需求,满足工艺要求,满足经济适用性。
热作模具钢除应具有高的强度,硬度,耐磨性和冲击韧性外,还应具有良好的高温强度,热疲劳性能和淬透性。

锻造操作机中的模具使用寿命研究在锻造行业中,模具是不可或缺的关键工具。
模具的使用寿命直接影响着生产效率和产品质量。
因此,对于锻造操作机中的模具使用寿命进行深入研究,能够帮助企业降低成本,提高生产效率,保证产品的质量。
一、模具使用寿命的定义和影响因素模具使用寿命是指模具能够保持良好工作状态直至失效的时间。
模具的使用寿命受多种因素的影响,包括:材料特性、锻造操作机工作条件、模具设计和制造质量、模具使用和维护等。
1. 材料特性:模具通常由高强度的合金钢制成,其硬度和强度对模具的使用寿命有重要影响。
一个合适的模具材料应具有足够的硬度和强度,以抵抗锻压力、磨损和冲击。
2. 锻造操作机工作条件:锻造操作机的工作条件,例如温度、压力和速度等,对模具的使用寿命有重要影响。
过高的温度和压力会引起模具的变形和磨损,影响模具的寿命。
3. 模具设计和制造质量:模具的设计和制造质量直接决定了其寿命。
合理的设计能够减少模具的应力集中和疲劳破坏,提高模具的使用寿命。
4. 模具使用和维护:正确的使用和维护能够延长模具的寿命。
例如,定期进行清洁和润滑,以减少磨损和摩擦。
二、模具使用寿命的研究方法和技术手段为了研究锻造操作机中模具的使用寿命,可以采用以下方法和技术手段:1. 实验研究:通过设计合适的实验方案,对模具在不同工况下的使用寿命进行测试和评估。
通过记录模具的失效情况以及对比不同工况下的使用寿命,可以分析模具的寿命规律并提出改进措施。
2. 数值模拟:利用计算机辅助工程软件,对模具在锻造操作机中的工作过程进行模拟。
通过数值模拟可以分析模具的应力和变形情况,预测模具的寿命,并探索优化设计方案。
3. 模具监测技术:利用传感器和数据采集系统对模具的工作状态进行实时监测。
通过收集和分析模具的工作数据,可以判断模具的使用寿命,并提前进行维护和更换,以避免意外的损坏。
三、延长模具使用寿命的措施为了延长锻造操作机中模具的使用寿命,以下措施可以被采取:1. 合理的模具设计:在模具设计过程中,应考虑到锻造操作机的工作条件和锻件的特性。

H13钢汽车热锻模具失效机理分析该批汽车热锻模具应用于轴类毛坯件的粗锻阶段,胚料初始温度1200~1300℃,由于热作模具的工作面往往与高温坯料直接接触,模具型腔的瞬时温度可达600~700℃。
另外,模具工作中需采用喷水冷却,持续时间大约在012~014s,这样使得模具在工作中产生周期性的温度变化,冷热交替循环易引起热疲劳。
模具使用寿命调查发现,使用寿命较短的热锻模具在1600~1800件,使用寿命较长的在5500~7000件,模具平均寿命在4000~5000件,寿命很不稳定,而国外同类模具使用寿命一般在1万件以上。
84锻压技术第33卷3热锻模具失效分析一般,导致热锻模失效的常见因素有3种:表面热磨损、高温氧化、热疲劳裂纹。
实际热锻模具的失效往往不是某种特定的单一模式,而是多种失效模式的综合,导致最终失效的成因较复杂。
311失效模具的宏观形貌从失效热锻模工作面宏观形貌观察,大部分失效热锻模表面都出现了不同程度的表面损失,表面磨痕清晰可见:沟痕、划伤、粘着磨损现象(图1a)。
除磨损外,还有大量的冷热疲劳裂纹,呈网状(龟裂状)或放射状分布,常出现在模具受载荷较大和冷热温度变化剧烈之处.也是热作模具中最为常见的一种疲劳失效形式(图1b)。
随着材料表面的氧化,氧化皮本身也起到磨料的作用,就决定了其磨损过程相当复杂。
失效模具表面出现的沟痕及磨损就是在这种剧烈的摩擦下产生的。
由于所锻造的零件为轴对称形状,可以观察到模具的磨损部位也基本呈对称分布。
由于冷热疲劳而失效的模具表面,肉眼可观察到网状分布的裂纹深浅不一。
某些局部的裂纹较大,最大裂纹总长度近5mm,大裂纹周边分布着许多细小的裂纹,裂纹由宽变窄,由边缘向内部延伸,最宽处近013mm。
另外还观察到由于氧化皮脱落,裂纹前端剥蚀严重,模具端部边缘失去尺寸等现象。
312裂纹处的显微形貌为进一步观察裂纹部位的细节,选取了具有典,用线切割机切割裂纹部位,10mm×10mm×6(SEM),不2所示。


关于模具使用寿命及失效问题分析摘要:在现代工业社会中,冷冲压模具生产方式是一种倍受青睐的现代工业品的加工方式,它的使用寿命直接影响着现代工业生产的效能与效率,它已是现代工业生产中的关键一环,因而它的使用寿命的提高也成为众多企业和专家学者研究课题。
关键词:模具使用寿命;失效问题;措施模具被人们称为工业之父,由于现代工业的自动化程度越来越高,模具的使用范围也越广泛,可在我国的较多中小企业中,其寿命还很低,仅相当于国外同行业的1/3到1/5。
模具的寿命低,不但会降低产品质量,更会产生浪费模具材料、增加加工工时等严重的后果,使产品的成本居高不下并严重影响生产效率。
1模具结构丧失功能的原因分析模具制品主要应用于工业生产,但时常会出现各类异常操作,进而导致模具结构定型功能的丧失,由此白白消耗大批的劳动工时,制约了生产效率的提升。
在此重点阐释模具制品失效的常见原因及常见的失效类型。
模具制品有多种失效模式,其中冷热型模具在使用过程造成功能丧失的几种主要表现是:在实际使用过程中模具结构产生塑性形变;模具工件内腔的摩擦损耗;模具材质疲劳;模具结构开裂。
1.1模具结构产生塑性形变模具结构所产生的塑性形变就是指其所承受的负载大小超出了依照其本身结构特点所设定的屈服强度指标并由此引发的模具结构形态改变,比如模具发生胎腔内陷、孔眼增大、棱角边缘坍落以及凸型模转变成镦粗型结构、竖向发生弯曲情况等。
特别是热加工型模具制品,它的有效工作表观层和高温型材料相接触产生摩擦及挤压过程,导致胎腔表观层温度一般都远远超出热加工模具钢材质的回火状态温度,胎腔内表面因为受热变软而被挤陷或挤成堆状。
冷镦型模具主要采用具有弱淬透性能的钢材,模具工件经过淬火预热之后,通过里孔实施喷水降温作业从而形成硬型保护层。
在模具工件使用过程中,倘若其受到的冷镦应力太强,其硬型表层下部的内壁耐压屈服性能不强,此时模具体内腔即被压坍。
模具工质的本身屈服能力通常随着碳元素的组分浓度随着某类合金成分的增大而上升,在硬度性能一样的状态下,不同组分含量的钢材质具备的抗压能力不一样,当钢体硬度指标为64HRC时,下面4类钢质的耐屈服能力从小到大的排列顺序是:5CrNiW<Cr6WV<Cr12<W18Cr4V。

浅谈热锻模具的失效摘要:本文主要探讨了热锻模具几种主要失效形式及产生的原因,为预防热锻模具的损坏和延长模具的使用寿命提供了相关的理论依据。
关键词:模具失效磨损裂纹1、引言模锻在锻造生产中占有十分重要的地位。
而模具的费用占模锻生产成本的比例在15%~20%。
因此模具的使用寿命一直受到锻造行业的高度重视。
而想要延长模具的使用寿命,那么我们首先就要了解模具是怎么失效报废的,找到模具失效的原因,才能采取相应的对策,使模具最大限度的延长使用寿命,从而降低模锻的生产成本,提高经济效益。
2、热锻模具失效的概念热锻模具的失效是指模具出现了不能通过修复手段来恢复其使用功能的损伤,也就是通常我们所说的模具损坏或报废。
热锻模具靠模膛使锻件毛坯成型,模膛直接与高温毛坯接触、承受脉冲式热负荷的作用,并承受锻压设备打击产生的高能冲击载荷和金属流动产生的摩擦力的作用,在模具的材料和设计加工水平正常及操作规范的情况下,模具的损坏大多数都发生在模膛部分。
这种失效通常称为“正常失效”。
模具的“正常失效”主要是机械应力和热应力的长期联合作用下,导致磨损、塑性变形或者出现裂纹或开裂所致。
当模具未达到现有技术水平下普遍公认的使用寿命时,通常称为模具的“非正常失效”,又称早期失效。
模具的“非正常失效”主要是因为模具材料冶金质量不合格、模具设计或制造工艺不当以及操作使用不当造成的。
早期失效包括模体脆性断裂、模膛塌陷和局部严重磨损等。
3、热锻模具失效的形式3.1 磨损磨损是模具在使用过程中,模膛表面与金属坯料接触产生相对运动,模膛表面金属逐渐被磨蚀的现象。
一般表现为刃口钝化、棱角变圆、平面下陷、表面沟痕、剥落黏模等。
而磨损的部位主要出现在模膛金属流动剧烈的转角处和飞边槽桥部,据统计,模具因磨损而报废的约占报废总数的70%左右。
一般磨损失效可分为以下几种形式:(1)疲劳磨损—模膛表面与变形金属表面相对运动时,在机械应力与热应力的作用下,使模膛表面金属疲劳脱落的现象。
模具的失效及使用寿命引言模具是工业生产中常见的重要工具,用于制造各种零件和产品。
然而,由于长时间的使用和外界环境的影响,模具会发生失效,并且其使用寿命也会受到一定的限制。
本文将探讨模具的失效原因和如何延长其使用寿命。
模具失效原因模具失效是指模具无法正常工作或无法满足生产需求的状态。
模具的失效原因可以分为以下几种:模具常常需要与材料接触,在长时间使用过程中,模具表面不可避免地会发生磨损。
磨损会导致模具尺寸偏差增大,使得制造的产品不符合要求。
疲劳疲劳是指模具在循环工作中受到反复加载引起的损伤。
长时间的循环工作会导致模具材料发生变形、龟裂甚至断裂,使得模具无法正常工作。
锈蚀模具在储存或使用过程中会与空气中的氧气与湿度接触,导致模具表面产生氧化反应,形成锈蚀。
锈蚀会导致模具表面粗糙,增加摩擦力并降低模具寿命。
模具在使用过程中,可能会遇到工件材料的结疤、套筒材料的残留物等堵塞问题。
堵塞会导致模具无法正常排出产品,影响生产效率。
温度模具在工作时会受到温度的影响。
温度过高会导致模具热胀冷缩不均匀,引起变形;温度过低会导致模具变脆,容易破裂。
延长模具使用寿命的方法虽然模具的失效是不可避免的,但可以采取一些措施来延长模具的使用寿命。
以下是几种常见的方法:定期保养定期保养是延长模具使用寿命的重要措施之一。
保养包括清洁模具、润滑模具以及进行各种维护工作。
定期保养可以有效减少磨损和锈蚀,延缓模具的失效。
控制模具工作环境模具的使用寿命与工作环境密切相关。
控制模具工作环境的温度、湿度和清洁度可以减少模具的疲劳和锈蚀,延长使用寿命。
使用合适材料选择合适的模具材料可以提高模具的抗磨损性能和抗疲劳性能。
同时,合适的材料还可以降低模具的摩擦力,减少磨损和温度影响。
加强培训和操作规范加强员工的培训和操作规范可以减少误操作,降低模具遭受损坏的风险。
培训员工正确使用模具和注意模具的保养,可以延长模具的使用寿命。
定期更换模具部件模具的部件往往是容易受损的部分,定期更换易损部件可以减少磨损的影响,并延长模具的使用寿命。
第18章锻件的损坏及其延寿措施三、锻模的损坏形式和提高寿命的措施1、锻模的损坏形式(1)锻模破裂锤击时,锻模受到冲击载荷,当产生的内应力超过材料的强度极限时,首先从应力集中处发生破裂。
从破裂的断口可以判断是疲劳破裂还是突然破裂。
突然破裂主要与锻模没有正预热有关。
(2)表面层热裂锻模在激冷激热的条件下,工作表面受到拉、压应力的交互作用,从而产生网状裂纹。
表面网状裂纹并不一定影响使用,但若这种裂纹出现在圆角或沟槽的应力集中处,则可能成为破裂的裂纹源。
(3)磨损模锻时金属在模膛中流动,与模膛表面强烈摩擦,造成模膛表面磨损,尺寸和表面状态均产生变化,达到一定程度即需要返修锻模。
锻模的磨损是锻模损坏的正常现象,但是良好的设计和操作可以显著延长锻模磨损周期,设计者主要应考虑成形时如何有利于金属的流动,操作者应注意在模锻时及时润滑锻模模膛,清除氧化皮以及随时修复锻模表面的任何缺陷等。
锻模的正常使用寿命见表8-16。
(4)变形在外力作用和温度影响下,模膛内局部软化而被压塌,使用模膛变形。
造成模膛变形的主要原因是锻模温度升高,或者初始热处理硬度偏低。
为避免锻模变形,模锻过程中应经常冷却、润滑锻模,不使锻件粘在模膛内,以免锻模局部温度过高。
2、提高锻模使用寿命的措施锻模的使用寿命与很多因素有关。
如锻模材料的组织和硬度,锻造温度和设备类型,锻模的结构设计以及锻模的冷却、润滑、使用等都直接影响锻模的寿命。
为了提高锻模的使用寿命,应采用以下措施:(1)模具材料方面选用耐磨、抗氧化、红硬性高、热疲劳性能好的模具材料,并采用正确的热处理规范。
对磨损严重的部位,可选用红硬性高的模具钢作镶块。
(2)模具设计方面设计上应保证金属流动合理,夹角部位应采用圆滑过渡;选用合理的镶块结构;制坯工步要合理;可对模具表面进行强化处理;保证锻模有足够的承压面积。
(3)使用方面在操作时必须严格按照规范预热、使用、冷却和润滑锻模。
防止低温锻造,及时清除氧化皮,严禁重锤空击。
锻造模具的失效与延寿
1.概述
模具在模锻件生产中占有特殊重要位置,只有高质量模具才可能生产出优质模锻件。
模具与锻件的“性价比”是企业技术和管理水平的综合反映,而模具寿命在“性价比”中期关键作用,即模具寿命直接影响锻件质量、成本、生产率及市场竞争力。
1.1模具寿命对锻件生产的影响
1.1.1模具寿命对锻件的质量的影响
众所周知,锻件精度与模具精度相匹配才能生产出合格锻件,并减少不良品率和废品率。
设计合理的预锻件(模具)和终锻件(模具)相对应的截面积、体积必须相匹配,否则锻件将因折叠或充不满而报废,也将加速模具磨损,而模具的磨损又直接影响锻件质量和尺寸的稳定性,从而增加后续加工的成本。
1.1.2模具寿命对锻件成本的影响
模具不仅影响锻件质量,而且影响锻件成本。
一般,模具费用约占锻件成本的10%-20%,日本和德国等发达国家占7%-15%,如德国1994年统计,模具成本占锻件销售额的11%。
模具价格昂贵,特别是大型模具,一整套125MN机械压力机生产线上的六拐8平衡块曲面分模曲轴模具(含辊锻、压扁、预锻、终锻、切边、热校正等工序)的总价约120万元,如果延长模具使用寿命20%,则锻件成本可降低2%-4%,为2.4万元-4.8万元。
企业实践表明,提高模具寿命是降低锻件成本的关键。
1.1.3模具寿命对锻件生产率的影响
生产中由于模具磨损和发生故障而进行模具修理、更换等损失时间约占实际生产时间的10%-15%,所以模具寿命影响生产率。
据国外全年统计,锻件企业24h生产,实际有效时间平均仅为16.5h,因此,模具寿命直接关系到锻件的质量、成本和生产率。
模具寿命长是实现锻件生产机械化和自动化的必备条件。
例如,世界上锻造生产率最高的日本,已有24%的锻造设备实现了机械化和自动化,生产率约185吨/人.年;德国和美国的生产率约80吨/人.年,而中国为(40-50)吨/人.年。
我国锻造生产率低的重要原因就是模具寿命、机械化和自动化程度低。
1.1.4模具寿命对企业竞争力的影响
锻件的交货周期直接影响企业的市场竞争力,而锻件的交货周期直接受模具制造周期及其寿命的影响。
模具寿命长则节约了更换和维修模具的时间,缩短锻件交货周期,可以按时或提前交付锻件。
一方面提升了企业的信誉,另一方面可以拿到要求交货周期短、原来不能承接的订单,从而提升企业的市场竞争力。
1.2锻造模具寿命现状
所谓模具寿命是指一套新模具从安装、生产、直至失效需要翻新前所生产的锻件数量,一般称正常寿命。
模具失效后经多次翻修的寿命之和为总寿命。
提高模具总寿命可节约模具材料(占模具成本的15%-40%),因此提高模具总寿命也是降低锻件成本的重要措施。
1.2.1国内外锻造模具使用寿命对比
对于低合金结构钢热模锻,日本德国等发达国家,按锻件复杂程度和精度,模锻锤模具寿命为0.5万件-0.8万件,但新型程控全液压模锻锤,由于其锻击能量和程序均可设定控制,模具寿命有所提高,0.6万件1万件。
机械压力机模具寿命一般可达到1万件-2.5万件,其中曲轴寿命为0.85万件0-1.8万件,连杆模具寿命为1万件-2.5万件,汽车转向节寿命为0.6万件-1.4万件,齿轮模具寿命为1.5万件-3万件。
个别极复杂、高精度的锻件模具寿命也仅为0.5万件-0.7万件。
螺旋压力机模具寿命比机械压力机稍低。
而国内大多数锻造企业模锻锤模具寿命为0.3万件-0.5万件,摩擦螺旋压力机模具寿命约为0.2万件-0.3万件,一般仅有0.2万件左右,机械压力机模具寿命为0.5万件-0.8万件。
发达国家的冷精密模锻模具寿命约为2万件-6万件,国内约为0.8万件-2.5万件。
相比之下,我国模具寿命仅相当于国外工业先进国家的1/3.
模具寿命是模具材料、设计和制造水平(含模具热处理和表面强化处理)及使用、维护水平的综合反映。
模具寿命的高低在一定程度上反映冶金工业、机械制造工艺与国外还存在一定差距。
1.2.2国外重视模具技术的实例
瑞典依玛特锻造厂用友25MN、40MN和160MN机械压力机,主要供应瑞典Volvo、意大利IVECO、德国MAN和美国GM汽车公司等世界著名汽车制造企业曲轴、前轴、转向节、连杆等锻件。
依玛特锻造厂能够在锻造行业始终保持领先水平一个重要原因就是他在发展锻造生产的同时,很注意发展锻模制造的新技术,讲锻模制造作为锻造生产的保证,真正发挥锻造生产大投资、高产出的优势。
160MN机械压力机年产曲轴20万件,前轴10万件,采用四班三运转每日24h生产,周六、周日不休息,设备负荷达到65%,其中模具寿命高是提高设备符合的决定因素。
2.锻造模具的失效
模具寿命的计算必然涉及到模具报废或失效的问题。
然而模具报废或失效至今尚无一个统一的标准,甚至一个企业内部不同管理人员之间所掌握的尺度也有很大差别,这会给企业造成巨大的资源浪费,直接影响到锻件生产。
2.1模具失效的概念
所谓模具失效是指模具出现了不能通过修复手段恢复其使用功能(不能继续使用)的损伤,即造成了通常所说的锻模的损坏或报废。
由于模具模腔起着成形锻件的功能,直接与炽热的坯料接触、承受脉冲式热负荷作用(热锻模具)、并承受锻压设备施加的高能量冲击载荷和毛坯金属流动冲刷以及润滑剂等环境介质的作用(热锻和冷锻模具),在模具的冶金和加工质量正常及规范操作情况下,锻模的损坏或报废绝大多数都发生在模膛部分,因此锻模的失效主要是在模膛出现了不能通过修理手段恢复其生产合格锻件的功能所致。
这种失效通常称为“正常失效”。
模具的“正常失效”主要是机械负荷和热负荷作用下,长期使用导致缓慢塑性变形、磨损或者疲劳裂纹所致。
当模具未达到现有工业技术水平下公认的寿命时,通常称为模具的“非正常失效”,又称早起失效。
模具的“非正常失效”主要是因为模具材料冶金质量不合格、锻造工艺或模具设计不当以及误操作等造成的。
早起失效主要有模体脆性断、模膛压塌(塑性变形)和局部严重磨损等。
2.2模具失效类型
2.2.1热锻模具的典型失效类型及其分析
按照磨损机理,磨损包括磨粒磨损、粘着磨损、疲劳(热疲劳与机械疲劳)磨损、氧化(腐蚀或化学)磨损。
研究锻模的失效是要找到失效的根本原因,采取预防措施,尽量避免早期和偶然失效,延长正常失效的时间。
热模锻模具失效类型
根据模具的磨蚀形式,典型的锻模正常失效类型有:磨蚀、热疲劳裂纹、机械疲劳裂纹、粘着和塑性变形。
当然,还有脆性断裂损坏,那是由于不正常操作或锻模先天质量不合格造成的,属于非正常破坏,属于早期失效或偶然失效。
1)磨蚀
在模锻加载过程中,模膛表面与热坯料的热传导加剧、金属流动与模膛表面摩擦产生巨大的热效
应,在二者的共同作用下,会引起很高的瞬间温升,产生氧化反应。
①热锻模具模膛表面各部位的摩擦和磨损主要取决于相应部位的受力状态,集合形状和表面粗糙
度等,根据各部位所受的负荷和金属流动特征,模膛表面大致可分为三个区域:压(应)力区(无
滑移区域死区)、剪切(应力)区(滑移区)和过渡区(微滑移区)。
②剪切(应力)区或称滑移区。
坯料相对于模膛表面剧烈流动,模膛承受坯料流动形成的剪切应
力作用,此外也还承受压应力的作用,该区的受力状态相当于镦粗工序的最大变性区。
该区(特
别是模膛表面已因回火而软化的部位)在金属流动的冲刷作用下,将模膛表面拉伤,形成与金属
滑移方向一致的沟槽。
③过渡区或成微滑移区。
一般位于滑移区和死区之间。
其受力状态和磨蚀特征都介于二者之间。
2)
(该内容是摘抄的,还未完全写好,稍后补上共同学习)。